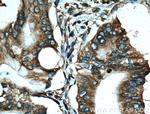

Search
Proteintech
EEF1D Monoclonal Antibody (3B1B11)
{{$productOrderCtrl.translations['antibody.pdp.commerceCard.promotion.promotions']}}
{{$productOrderCtrl.translations['antibody.pdp.commerceCard.promotion.viewpromo']}}
{{$productOrderCtrl.translations['antibody.pdp.commerceCard.promotion.promocode']}}: {{promo.promoCode}} {{promo.promoTitle}} {{promo.promoDescription}}. {{$productOrderCtrl.translations['antibody.pdp.commerceCard.promotion.learnmore']}}
产品信息
60085-1-IG
种属反应
已发表种属
宿主/亚型
分类
类型
克隆号
抗原
偶联物
形式
浓度
规格
纯化类型
保存液
内含物
保存条件
运输条件
产品详细信息
The calculated molecular weight of EEF1D is 31 kDa, but the modified protein is about 35-40 kDa.
Immunogen sequence: SHRPGPRSG LSVSSLRPNR KMATNFLAHE KIWFDKFKYD DAERRFYEQM NGPVAGASRQ ENGASVILRD IARARENIQK SLAGSSGPGA SSGTSGDHGE LVVRIASLEV ENQSLRGVVQ ELQQAISKLE ARLNVLEKSS PGHRATAPQT QHVSPMRQVE PPAKKPATPA EDDEDDDIDL FGSDNEEEDK EAAQLREERL RQYAEKKAKK PALVAKSSIL LDVKPWDDET DMAQLEACVR SIQLDGLVWG ASKLVPVGYG IRKLQIQCVV EDDKVGTDLL EEEITKFEEH VQSVDIAAFN KI (347-647 aa encoded by BC007847)
靶标信息
This gene encodes a subunit of the elongation factor-1 complex, which is responsible for the enzymatic delivery of aminoacyl tRNAs to the ribosome. This subunit functions as guanine nucleotide exchange factor. It is reported that this subunit interacts with HIV-1 Tat, and thus it represses the translation of host-cell, but not HIV-1, mRNAs. Several alternatively spliced transcript variants encoding multiple isoforms have been found for this gene.
仅用于科研。不用于诊断过程。未经明确授权不得转售。
生物信息学
蛋白别名: Antigen NY-CO-4; EEF 1D; EF 1 delta; EF 1D; EF-1-delta; Elongation factor 1-delta; eukaryotic translation elongation factor 1 delta (guanine nucleotide exchange protein); guanine nucleotide exchange protein; translation elongation factor 1-delta subunit; unnamed protein product
基因别名: EEF1D; EF-1-delta; EF-1D; EF1D; FP1047; NEDTCHAL
UniProt ID: (Human) P29692, (Mouse) P57776, (Rat) Q68FR9
Entrez Gene ID: (Human) 1936, (Mouse) 66656, (Rat) 300033